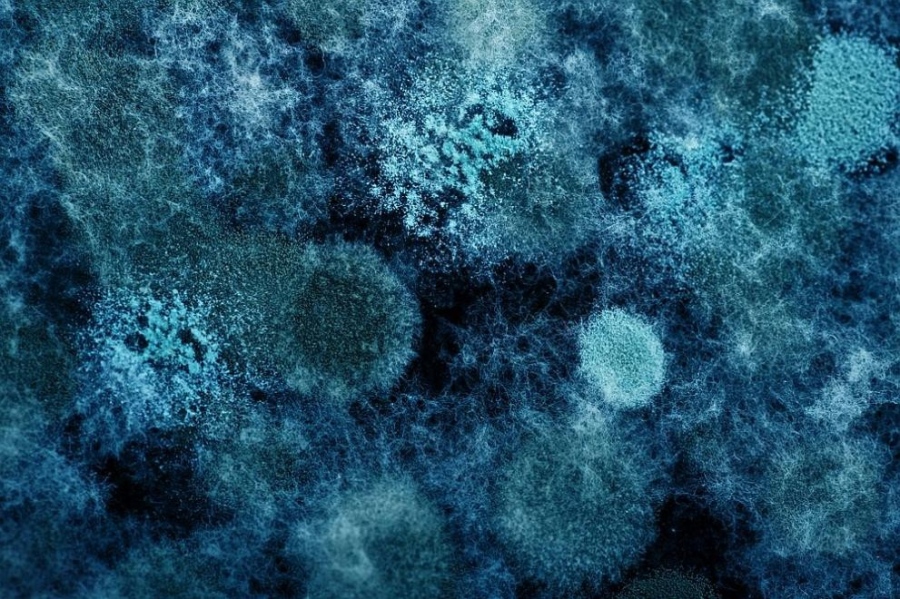

Живи микроорганизми биха могли да пътуват между планетите върху космически отломки, съобщава „Сайънс нюз“, като цитира учени от САЩ, които са публикували своите изследвания в сп. Proceedings of the National Academy of Sciences (PNAS).
Тези изследвания са в подкрепа на тезата, че животът на Земята може да е дошъл от космоса, тъй като градивните елементи на живота – ДНК, аминокиселини и други биомолекули, се откриват в комети, астероиди и космически прах.
Експериментите също показват, че някои микроорганизми оцеляват безпроблемно в екстремните условия на космоса. Според хипотезата за панспермията животът на Земята може да е възникнал именно чрез такива „пътешественици“, пренесени върху астероиди или метеорити.
„Марсианските метеорити, открити на Земята, доказват, че материал, изхвърлен при удар, може да пътува от Марс до Земята“, обясняват Лили Чжао от Университета „Джонс Хопкинс“ в Балтимор и нейните колеги. За да е възможно това, микробите трябва да издържат както на огромното налягане и топлина при удара, така и на дългото пътуване в космоса.
За да проверят това, изследователите провеждат експеримент с една от най-устойчивите известни бактерии – Deinococcus radiodurans, наричана още шеговито „Конан бактерията“. Тя може да преживява силна радиация, екстремен студ и суша, а вероятно и вакуум. Бактериите са поставени между две метални плочи във вакуум и подложени на удари от газово оръдие, създаващи налягане от 1 до 3 гигапаскала – сравнимо с налягането при метеоритни сблъсъци.
Резултатите изненадват учените. При налягане от 1,4 гигапаскала оцеляват над 95 процента от клетките, при 1,9 гигапаскала – около 90 процента, а при 2,4 гигапаскала – около 60 процента. Дори когато металната рамка на експерименталната установка се разпада, част от бактериите остават живи.
По-подробният анализ показва, че при по-ниско налягане клетките почти не са увредени. Генетичните изследвания разкриват, че бактерията активира специални гени за възстановяване на ДНК и на клетъчните структури, като временно потиска растежа и деленето, за да се съсредоточи върху регенерацията.
Според учените това означава, че някои микроорганизми могат да преживеят по-екстремни условия, отколкото се смяташе досега – включително ударите, които изхвърлят материал от една планета към друга. „Това подсказва, че животът може да прескача между планети“, казва Чжао. „Може би всички ние всъщност сме марсианци.“
Откритията имат значение и за космическите мисии. Въпреки строгите правила за стерилност на космическите апарати, способността на някои микроби да оцеляват при такива условия показва, че мерките срещу биологично замърсяване на други планети може да трябва да бъдат още по-строги, отбелязват учените.
//dariknews.bg/